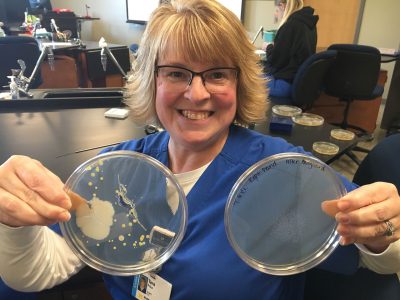
Tera Price, former Kirtland student and namesake of the Tera Price Memorial Scholarship

Kirtland Foundation announces Scholarship Fund to support student scholarships
The Kirtland Foundation, an independent nonprofit that raises money for grants and scholarships for Kirtland Community College students, faculty and staff, today announced the new Kirtland Foundation Scholarship Fund Campaign.
The campaign, which began in July 2019, aims to raise $225,000 in order to create 100 new scholarships for students who attend Kirtland Community College. Over $95,000 has been raised so far, making up 42% of the goal. The new campaign is expected to triple the amount of scholarships available for students in 2020 and beyond, as 50 scholarships were provided by the Foundation last year.
“Students deserve to pursue their dream careers, but often face significant barriers to getting the necessary education. Over 84% of students at Kirtland receive financial aid, but that often isn’t enough,” said David Lepper, Director of the Kirtland Foundation, “We’re aiming to close the gap between student aid and college costs in order to attract and retain more students.”
As over 75% of jobs in the next five to ten years are expected to require postsecondary education, the Foundation aims to strengthen the community and economy by making college more accessible, helping fill key jobs in the area with skilled graduates. Started in 1972, the Kirtland Foundation raises funds from private donors, local businesses, alumni and more to provide financial support for students.
Many scholarships have been created in memory of donors’ family, such as the Tera Price Memorial Scholarship. A student in Kirtland’s surgical technology program, Tera Price had a passion for the field and encouraging her fellow students. After she passed away from cancer in May 2019, her longtime companion Bob Stewart established the scholarship so that other students could pursue their dreams like Tera.
Ariane, a nursing student who received the Otto and Martha Krauss Health Sciences scholarship this fall said, “I work two part-time jobs so I can pay my way, and this scholarship was the difference between make or break for me.”
Eligibility differs for each scholarship offered, but students are selected for scholarships based on need, educational goals, community involvement, and letters of recommendation. To apply for scholarships, students can visit https://www.kirtland.edu/foundation/scholarships/. To contribute to the campaign, contact David Lepper at [email protected] or visit the Foundation’s website at kirtland.edu/foundation/donate.
About Kirtland Community College
Established in 1966, Kirtland Community College is a two-year college that serves over 17 communities as the largest Michigan community college district. The college offers 38 degrees and certifications across four campuses, and continuously strives to adapt programming to meet economic demands. By fostering a culture of innovation, Kirtland equips students with the tools they need to succeed in fulfilling careers. https://www.kirtland.edu/
About the Kirtland Foundation
As an independent 501(c)(3) organization, the Kirtland Foundation raises money from private donors, local businesses, alumni and more, then allocates funds in the form of scholarships and grants to Kirtland Community College students and faculty and staff. Last year the foundation awarded over 50 scholarships to Kirtland Students, including first-year students, non-traditional students, part-time students, veterans and more. https://www.kirtland.edu/foundation/
New Scholarships
Edward G. and Marquita L. Rothe Endowed Scholarship Fund
- Donor(s): Ed, Elaine and Darby Harris (Gaylord)
- To benefit students who are enrolled in the KCC Michigan Forest Products Institute and Wood Science Technology Program and/or related wood programs.
Ron and Sharon Beyer Endowed Scholarship Fund
- Donor(s): Lindsey and Kim Levine
- To benefit students who are enrolled in nursing or automotive technology programs
Dick and Ilene Lepper Scholarship
- Donor(s): David and Midge Lepper (Houghton Lake)
- To benefit students from the Houghton Lake area.
Curnalia Scholarship
- Donor(s): Bill and Anne Curnalia (Roscommon)
- To benefit any student enrolled in good standing at KCC
Higgins Lake DQ Scholarship Fund
- Donor(s): Matt and Mary Jo Buschbacher (Roscommon)
- To benefit students from Grayling and Roscommon High Schools
The Woods Family Scholarship
- Donor(s): Sandra Woods, BSN, RN, MSA (Roscommon)
- To benefit health care students with a minimum GPA of 3.2
Blarney Stone Broadcasting Scholarship
- Donor(s): Blarney Stone Broadcasting (Grayling)
- To benefit students in marketing and communications
Wahl Family Scholarship
- Donor(s): Michael Wahl (Saint Helen)
- To benefit students who live in KCC District who have at least 30 credits, are at least 30 years old and have a 3.0 GPA or better
Carlee Cournyer Allen Scholarship Fund
- Donor(s): Pauline Cournyer (Mio)
- To benefit students from Mio enrolled in any program
Hart Ford Lincoln Automotive Technology Scholarship Fund
- Donor(s): Hart Ford Lincoln (Roscommon)
- To benefit students from Crawford, Oscoda, Ogemaw or Roscommon counties and are enrolled in the Automotive Technology Program at KCC.
The Bill Ross Memorial Scholarship
- Donor(s): Au Sable North Branch Foundation (Lovells)
- To benefit students residing in Lovells Township and/or Crawford County. Students must have a GPA of 2.5 or higher.
KCC Board of Trustees Scholarship Fund
- Donor(s): KCC Board of Trustees members and former members
- To benefit deserving students who are attending KCC
Thomas and Cheryl Quinn Fast Act Scholarship
- Donor(s): Thomas and Cheryl Quinn (Houghton Lake)
- To provide small scholarships, on short notice, to help students who do not have financial means to deal with emergency issues that may affect their ability to continue and/or complete their education at KCC.
Tera Price Memorial Scholarship
- Donor(s): Bob Stewart (Harrison)
- To provide scholarships for students enrolled in the Surgical Technology Program at KCC.
Northern Family Dentistry Health Professions Scholarship
- Donor(s): Northern Family Dentistry (Roscommon)
- To benefit KCC students enrolled in any Health Professions program at Kirtland Community College.
Jim’s Collision Automotive Technology Scholarship
- Donor(s): Jim’s Collision (Roscommon)
- To benefit Kirtland Students enrolled in the Automotive Technology Program and who live in the KCC district.
David F. Schelter Scholarship Fund
- Donor(s): Bill and Susie Marshall (Gaylord)
- To benefit KCC students from the Gaylord area and are enrolled in English.
Kirtland Retiree Scholarship Fund
- Donor(s): All KCC retirees
- To benefit deserving students who are attending KCC
Scholarship Recipients
- Makayla Bowler of Roscommon, The Keith Rich Trust
- Jonathan Coomer of Atlanta, Robert (Bob) Doan Scholarship
- Chandler Diehl of West Branch, Ron & Melanie Marino memorial Scholarship
- Stephanie Dillon of West Branch, Kirtland Foundation General Scholarship
- Angela Erber of Roscommon, Marquerite D. Wiltse Memorial Scholarship
- Alexis Evans of Gaylord, Kirtland Foundation General Scholarship
- Anne Fila of Grayling, Robert Bovee Scholarship for Health Sciences
- Brittany Harwood of Frederick, Patricia Hill Nursing Scholarship
- Ariane Hawkins of Gaylord, Otto & Martha Krauss Health Sciences Scholarship
- Rickey Heavner of Grayling, Anna Biernat Scholarship
- Nicole Huck of Roscommon, Otto & Martha Krauss Health Sciences Scholarship
- Cayla Killinger of Houghton Lake, Herbert & Evelyn Miller Scholarship
- Tabitha Kirby of Boyne Falls, Kirtland MS/Kirtlend Endowment
- Daniel Lahey of Mio, Carl Fernelius Memorial Scholarship
- Michelle Magnus of Beaverton, Veterans Helping Veterans at KCC
- Renae Marcott of Kingsley, Kirtland Foundation General Scholarship Fund
- Delana Price of Lewiston, Kirtland Foundation General Scholarship Fund
- Isabella Sieman of Gaylord, Otto & Martha Krauss Health Sciences Scholarship
- Megan Smith of St. Helen, Otto & Martha Health Sciences Scholarship
- Caitlyn Smith-Willor of Rose city, Lawson F. & Anna L Chambers Scholarship
- Hannah Smock of Grayling, Donald N Fenton Memorial Scholarship
- Paxton Spencer of Standish, Marguerite Gahagen Scholarship
- Skyla Stachnik-Ryckman of Gaylord, Patrick J. Trahan Memorial Scholarship
- Caleb Terrian of Grayling, Anna Biernat Scholarship
- Katie Williams of Grayling, James D. Fryfogle Memorial Scholarship
